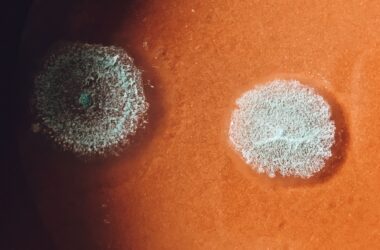
Qué es un sesgo cognitivo y cómo nos afecta?

¿Qué es la
psicoterapia?
Es un proceso terapéutico cuyo fin último es aliviar el sufrimiento psicológico de la persona.
En sentido positivo, la psicoterapia es un proceso de acompañamiento orientado al crecimiento personal, vale decir, un apoyo para promover los propios recursos, el autoconocimiento y el desarrollo de nuevas habilidades que ayuden a la persona a aumentar su bienestar.
La psicoterapia también se puede entender como un espacio clínico donde se abordan de forma sistemática problemáticas propias de trastornos psicológicos específicos, tales como como la depresión, trastornos relacionados con la ansiedad, y procesos vitales dolorosos o traumáticos como duelos, conflictos relacionales, y otros.
En psicología se dice habitualmente que «el vínculo es lo que sana». En mi calidad de profesional creo que este es uno de los aspectos fundamentales de la intervención, establecer un vínculo basado en el respeto hacia los propios intereses, tiempos y necesidades de la persona. Este vínculo se funda en, la empatía, mediante la escucha activa, el compromiso y la suspensión del juicio. Esto permite establecer un vínculo sano y reparador que facilita y acompaña en el proceso terapéutico.